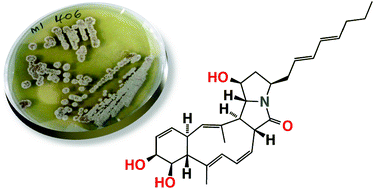

A Streptomyces sp. isolated from a shallow water sediment sample collected off Heron Island, Australia, afforded three new polyketide macrolactams, heronamides A–C (1–3). Structures were assigned to the heronamides on the basis of detailed spectroscopic analysis, chemical derivatization and biosynthetic considerations. A plausible biosynthetic pathway is proposed in which key carbocyclic ring transformations proceed via an unprecedented synchronized tandem electrocyclization. This biosynthesis provides a framework for the assignment of complete relative configurations across all heronamides, and inspires an attractive biomimetic strategy for future total syntheses. Heronamide C elicits a dramatic and reversible non-cytotoxic effect on mammalian cell morphology.